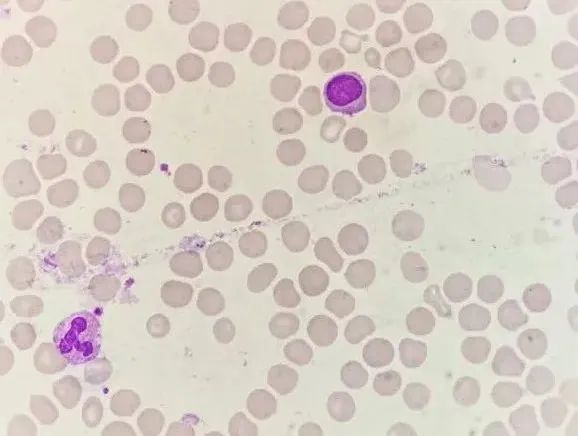

发现「延长TT」,做好MM的「吹哨人」
「一场春雨,一缕清风,一簇花开。
难得三月好风光,满阶芳草绿,一片杏花香。」
如此美好的三月,却因一张看似不起眼的报告单数据戛然而止。
3月22号,下午两点是值班的我正被困意席卷的时段,凝血岗的老师说:“李老师,这个患者啥啥都正常,唯独TT(下图)延长一丢丢,是我出了什么问题么?还是另有原因”?我还玩笑似的回她:“现在被我带的都成了惊弓之鸟了”。
玩笑归玩笑,有异常还是要找下原因的。
话落我便和凝血岗老师一起寻找TT延长的原因。
当天质控在控,试剂无误,标本外观无异常。反应曲线无异常。
其他检查结果如下:
查看病例如下:
随后电话联系患者本人,既往无出血及血栓史,未服用任何药物。
那就奇怪了,什么原因导致的TT轻度延长呢?
正在纳闷,患者本人就颤颤巍巍到窗口来找我了,异样紧张的问:“医生,我这是有啥事么?我平时没啥病,就是骑三轮车买菜的时候,被停在路边的车主开车门撞了翻了,现在检查了一遍也没啥毛病,你刚才给我打电话说我这血检查是咋啦?我是不是有啥绝症了?我父亲多年前死于多发性骨髓瘤,查出来一年不到人就走了,我不会是遗传,也是多发性骨髓瘤吧?”
听到患者说其父亲为多发性骨髓瘤病故,心里不禁打了个寒颤,回想这些年我们遇到的多发性骨髓瘤有不少是以TT延长或测不出被发现(不过没有相关研究数据说多发骨髓瘤遗传这回事,最多也只是有易感因素),这时患者又紧张地说:“你帮我查一下吧,该查啥查啥,可别是我父亲那样的病了”。
于是建议患者检查血清电泳。并同时复查血常规及加做血涂片镜检。血涂片未见红细胞缗钱样改变、未见典型浆细胞。

两天后外送电泳结果如下:


◂ 左右滑动查看 ▸
真是怕啥来啥,这电泳结果还真的是不排除多发性骨髓瘤。
随后该患者转至上级医院,最终被确诊为多发性骨髓瘤(早期)。
凝血酶时间 (thrombin time, TT)检测原理:37℃条件下,在待检乏血小板血浆中,加入标准量凝血酶后,直接将纤维蛋白原转变为纤维蛋白所需的时间即为凝血酶时间。
延长常见于三大类情况:
01 血浆纤维蛋白原质或量异常;
02 临床应用凝血酶抑制剂(如肝素、达比加群酯等)、患者体内病理性肝素样抗凝物质增多、患者体内存在抗凝血酶抗体;
03 FDP、单克隆免疫球蛋白增高。
MM多是由于B淋巴细胞中的恶性细胞肿瘤终末分化,使得患者体内生成大量的单克隆免疫球蛋白。部分MM患者合并有凝血指标的严重异常,最终引起出血。
单克隆免疫球蛋白导致凝血异常的机制较为复杂:
01 M蛋白抑制带负电荷凝血酶的结合位点,IgG与凝血酶的结合加速了抗凝血酶-凝血酶反应,从而延长了凝血酶时间;此外,IgG抑制凝血酶激活因子VIII,并可能通过干扰因子IXa VIIIa复合物的形成从而延长aPTT。
02 M蛋白可包裹在血小板表面,封闭受体,影响纤维蛋白多聚化,干扰正常的凝血过程,影响血小板功能。
03 多发性骨髓瘤患者体内类肝素样物质。
04 浆细胞骨髓浸润,使造血功能受抑,引起血小板减少。
05 高免疫球蛋白血症和淀粉样变性造成的血管壁损伤。
综上所述本例患者TT的延长可能为异常的M蛋白所致 。这是一例看似不起眼轻度延长的TT,但其背后可能真的是为临床“吹了哨”,在审核异常凝血报告单的时候,我们一定要多思考、多沟通,做好临床的“吹哨人”。